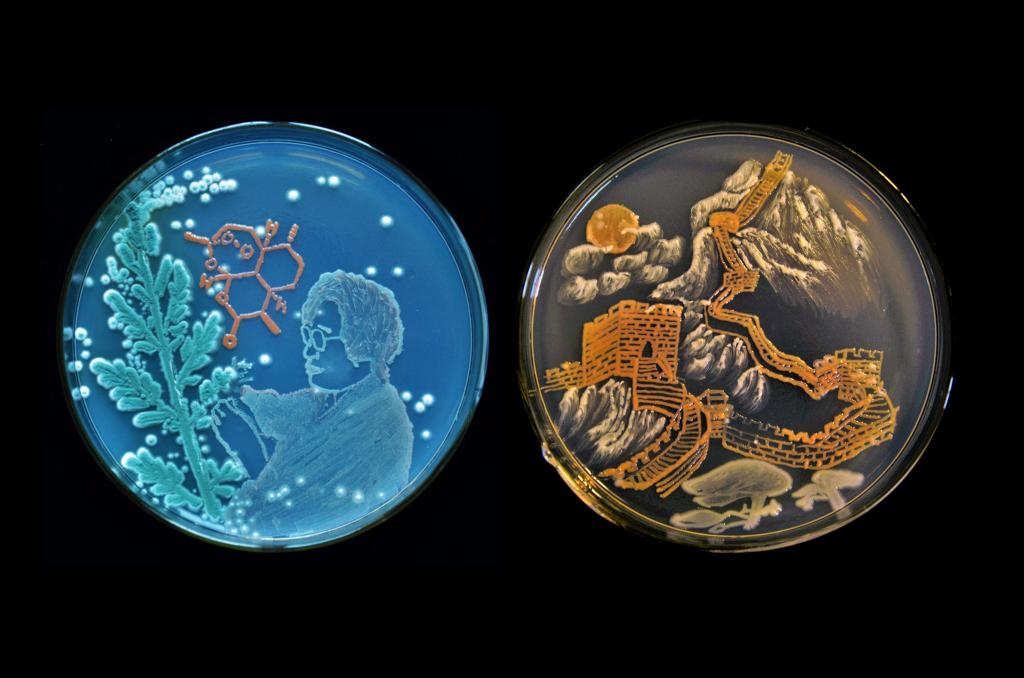

5月12日,第六届全国青年科普创新实验暨作品大赛合肥赛区复赛获奖名单(生物环境,大学组)出炉,永利官网 7件作品获奖,其中一等奖1项、二等奖1项、三等奖3项、优秀奖2项。77779193永利科学技术协会获得优秀组织奖。
经过多轮激烈角逐,由牛顿团队创作的《雅荷》斩获大学组一等奖;孙青团队创作的《呦呦青蒿》获得大学组二等奖;牛顿团队创作的《映雪红梅》、张琪团队创作的《国之脊梁》、万蒙杰团队创作的《学习强国》获得大学组三等奖;崔燕团队创作的《生命的伦理》、佟飞雨团队创作的《松鹤雾宕》获得大学组优秀奖。

“做科研是一件较为枯燥的事情,所以学生们就利用微生物在不同培养皿中可产生不同颜色的特质,再结合自己的创意,‘绘制’出各种图案。”团队指导老师黄祝介绍,一幅微生物画作要经过几个月甚至半年的准备和创作,创作过程中团队成员需对作品进行无数次的实验和修正,以确保画作的颜色和形态达到理想效果。“学生们将科学与艺术相融合,不仅把科学研究变得丰富有趣,取得的成果也是令人非常欣慰的。”
全国青年科普创新实验暨作品大赛作为教育部认可的29项面向全国学生的赛事活动之一,今年在全国设十五个分赛区,其中合肥赛区由安徽省科技馆承办,主要面向安徽省、浙江省和上海市的大学生和中学生开展比赛。此次生物组比赛设置一等奖一名,二等奖两名,三等奖三名,优秀奖四名。永利官网牛顿团队创作的《雅荷》将于五月底参加全国大学生生物组决赛。(文/学生记者 胡雅丽 图/胡迎峰 李梦洁)

 安徽安庆菱湖南路128号
安徽安庆菱湖南路128号 邮编:246011
邮编:246011 安徽安庆集贤北路1318号
安徽安庆集贤北路1318号 邮编:246133
邮编:246133